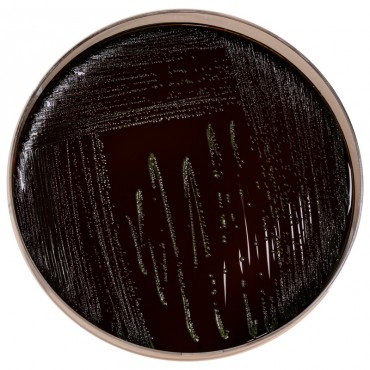

- +Produits
- +Consommables de laboratoire
- +Équipement de laboratoire
- +Équipement pour la microbiologie
- +Milieux de Culture - réactifs et trousses de performance
- +Solutions de sécurité alimentaire Neogen®
- +Systèmes de surveillance des températures et de l'humidité
- +Tests d'allergènes
- +Tests environnementaux
- +Services
- SUPPORT
- Nouvelles
- +À propos de nous
- Contact

Supplément sélectif Palcam
La gélose PALCAM est un milieu sélectif utilisé pour la différenciation et l’isolement de Listeria monocytogenes et des autres Listeria dans les produits alimentaires tels que le lait et les fromages, ainsi que dans les autres denrées alimentaires même fortement contaminées.
Le milieu peut être utilisé comme second milieu au choix dans le cadre de la méthode de recherche de Listeria monocytogenes en microbiologie des aliments (NF EN ISO 11290-1). La gélose PALCAM peut également être utilisée comme test de confirmation de Listeria spp dans la méthode
COMPASS Listeria.
Suppléments :
BS00408 disponible en 10 flacons qsp 500 ml
BS04908 disponible en 8 flacons qsp 2,5 L
Les peptones et l’extrait de levure favorisent une excellente croissance des Listeria.
Le glucose et l’amidon représentent les sources énergétiques de la croissance bactérienne.
Le chlorure de sodium maintient l’équilibre osmotique.
Les Listeria hydrolysent l’esculine en glucose et en esculétine. L’esculétine produite forme un complexe noir en présence des ions ferriques apportés par le citrate de fer. La microflore secondaire est inhibée par l'association entre le chlorure de lithium, la ceftazidime, la polymyxine et l’acriflavine (colorant antiseptique).
La fermentation du mannitol par les germes contaminants qui pourraient cultiver est mise en évidence par le virage au jaune du rouge de phénol, permettant ainsi d’orienter le diagnostic.
Produits connexes